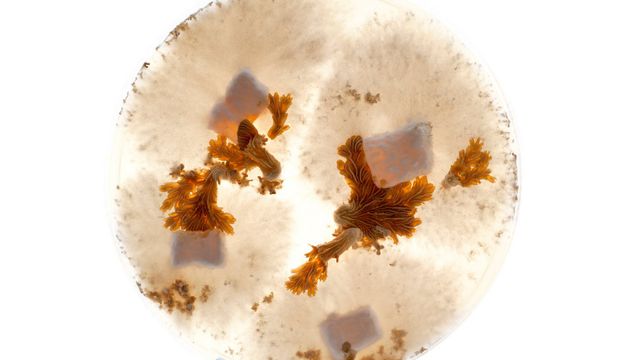
Sopp skal øke utvinningen

Olje og gass

Lovende for oljemygger i Barentshavet

Stans på Njord etter gasslekkasje
Sopp skal øke utvinningen

BP blar opp milliarder

Statoil interessert i Ukraina
39616_21_17_Cropped%25201104131326.jpg)
Fant igjen vinnersporet

Dette er gullblokkene

Skal lete under basalten

Stortildeling i Barentshavet

Kina holder tilbake skifergass

– Gammel konsekvensutredning holder ikke

Enighet om Shtokman-konsept
35409_14_21%25201103090838.png)
Henrik O. Madsen: Brenner for det kalde

Vil ha nye gullblokker
